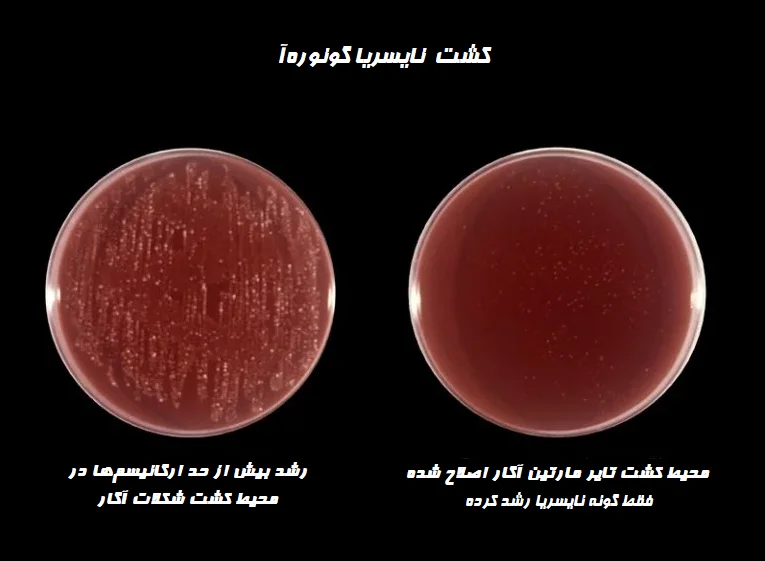
تفسیر نتیجه تایر مارتین آگار اصلاح شده

ابزار و وسایل آزمایشگاهی شامل، محلول ها کیت ها,ویکی ژن
تایر مارتین آگار اصلاح شده (Modified Thayer Martin Agar): ترکیب، اصول، روش آمادهسازی، نتایج و موارد استفاده
مقدمهای بر تایر مارتین آگار اصلاح شده
Thayer و Martin یک بهبود در فرمول شکلات آگار را گزارش کردند که حاوی مواد ضدمیکروبی وانکومایسین (Vancomycin)، کولیستین (Colistin) و نیستاتین (Nystatin) برای به حداقل رساندن رشد بیش از حد آلایندهها، سرکوب رشد ساپروفیت (Saprophytic) گونه نایسریا (Neisseria) و افزایش رشد نایسریای بیماریزا میباشد.
مارتین (Martin) و لستر (Lester) بعداً آنتیبیوتیک تریمتوپریم (Trimethoprim) را برای افزایش انتخابی بودن محیط اضافه کردند و نشان دادند که در سرکوب گونههای پروتئوس (Proteus) موثر است.
تریمتوپریم لاکتات (Trimethoprim lactate) از رشد پروتئوس جلوگیری میکند. محیط بدست آمده تایر مارتین اصلاح شده نام دارد. تایر مارتین آگار اصلاح شده یک محیط انتخابی و غنیشده برای جداسازی و کشت گونه نایسریا از فلور (flora) مختلط با سرکوب اکثر دیپلوکوکهای (diplococci) گرم منفی دیگر، باسیلهای گرم منفی، ارگانیسمهای گرم مثبت و مخمر میباشد.
ترکیب تایر مارتین آگار اصلاح شده
| مواد تشکیل دهنده | مقدار |
| کازئین پپتون (Casein peptone) | 7.5 گرم |
| میت پپتون (Meat peptone) | 7.5 گرم |
| نشاسته ذرت | 1 گرم |
| دیپتاسیم فسفات (Dipotassium Phosphate) | 4 گرم |
| مونوپتاسیم فسفات (Monopotassium Phosphate) | 1 گرم |
| کلرید سدیم | 5 گرم |
| آگار | 12 گرم |
| محلول هموگلوبین | 10 گرم |
| غنیساز ایزوویتال ایکس (IsovitaleX) | 10 میلیلیتر |
| وانکومایسین | 300 میکروگرم |
| کولیستین | 750 میکروگرم |
| نیستاتین | 12,5 U |
| تریمتوپریم (Trimethoprim) | 5 میلیگرم |
| آب دمینرال شده | 1000 میلیلیتر |
pH نهایی در دمای 25 درجه سانتیگراد: 2/0 ± 2/7
غنیساز ایزوویتال ایکس
| دکستروز (Dextrose) | 100 گرم |
| ویتامین 12B | 0.01 گرم |
| ال-گلوتامین (L-Glutamine) | 10.0 گرم |
| تیامین هیدرو کلریک (Thiamine HCl) | 0.003 گرم |
| ال سیستین (L-Cystine) | 1.1 گرم |
| آدنین (Adenine) | 1.0 گرم |
| p- آمینوبنزوئیک اسید (p-aminobenzoic acid) | 13 گرم |
| کوکربوکسیلاز | 0.1 گرم |
| سیستین هیدرو کلریک (Cystine HCL) | 25.9 گرم |
| گوانین هیدرو کلریک (Guanine HCL) | 0.03 گرم |
| NAD | 0.25 گرم |
| نیترات آهن (Ferric nitrate) | 0.02 گرم |
| آب دمینرال شده | 1000 میلیلیتر |
آمادهسازی تایر مارتین آگار اصلاح شده
-
آمادهسازی GC آگار بیس (GC Agar Base)
- اجزای محیط GC بیس را به آب مقطر اضافه و حجم را به 730 میلیلیتر برسانید. خوب آن را مخلوط کنید. محیط را به آرامی حرارت داده تا به جوش آید، سپس در دمای 121 درجه سانتیگراد به مدت 15 دقیقه اتوکلاو کنید. اجازه دهید محیط تا دمای 45 تا 50 درجه سانتیگراد خنک شود.
-
آمادهسازی محلول هموگلوبین
- هموگلوبین را به آب مقطر اضافه کنید و حجم آن را به 250 میلیلیتر برسانید. کاملا آن را مخلوط کنید. در دمای 121 درجه سانتیگراد به مدت 15 دقیقه اتوکلاو کنید. اجازه دهید محیط تا دمای 45 تا 50 درجه سانتیگراد خنک شود.
-
آمادهسازی غنیساز ایزوویتال ایکس (10 میلیلیتر)
- مولفههای ترکیب را به آب مقطر اضافه کنید و حجم را به 10 میلیلیتر برسانید. کاملا مخلوط کنید. با فیلتر آن را استریل کنید.
-
تهیه محلول آنتیبیوتیک VCNT (10 میلیلیتر)
- مولفههای ترکیب را به آب مقطر اضافه کنید و حجم را به 10 میلیلیتر برسانید. کاملا مخلوط کرده و با فیلتر آن را استریل کنید.
آمادهسازی محیط
- به 730 میلیلیتر از GC آگار بیس سرد شده و استریل، 250 میلیلیتر محلول هموگلوبین استریل را به صورت آسپتیک (Aseptic) اضافه کنید. 10 میلیلیتر غنیساز ایزوویتال ایکس و 10 میلیلیتر محلول آنتی بیوتیک VCNT به آن اضافه کنید. کاملا محیط را مخلوط کرده و در ظروف پتری استریل بریزید یا در لولههای استریل توزیع کنید.
اصول تایر مارتین آگار اصلاح شده

تایر مارتین آگار اصلاح شده بر پایه آگار شکلات II (Chocolate II Agar) است که حاوی GC آگار بیس بهبود یافته، هموگلوبین گاوی و یک غنیساز است. GC II بیس حاوی مواد مغذی نیتروژندار به شکل کازئین و میت پپتونها، بافر فسفات برای حفظ pH و نشاسته ذرت است که اسیدهای چرب سمی موجود در آگار را خنثی میکند. دکستروز برای تقویت رشد گونوکوک (Gonococci) اضافه میشود.
هموگلوبین، فاکتور X (همین (Hemin)) را فراهم میکند. غنیساز ایزوویتال ایکس یک مکمل تعریفشده است که فاکتور V (نیکوتینآمید آدنین دینوکلئوتید (Nicotinamide adenine dinucleotide (NAD)))، ویتامینها، اسیدهای آمینه، کوآنزیمها، دکستروز، یون آهن و سایر عواملی را که باعث بهبود رشد نایسریا بیماریزا میشوند، فراهم میکند.
این محیطهای انتخابی حاوی عوامل ضد میکروبی وانکومایسین، کولیستین و نیستاتین (مهارکننده V-C-N) برای سرکوب فلور طبیعی هستند. وانکومایسین عمدتاً علیه باکتریهای گرم مثبت فعال است. کولیستین باکتریهای گرم منفی از جمله گونه سودوموناس (Pseudomonas) را مهار میکند. ثابت شده که تایر مارتین آگار، کاندیدا آلبیکنس (Candida albicans) را مهار میکند. تریمتوپریم لاکتات از ازدیاد گونههای پروتئوس جلوگیری میکند.
تفسیر نتیجه تایر مارتین آگار اصلاح شده
مورفولوژی کلنی نوعی در این محیط به شرح زیر است:
- نایسریا گونورهآ (Neisseria gonorrhoeae): کوچک، سفید مایل به خاکستری تا بیرنگ، موکوئیدی (Mucoid) با قوام ملایم و حاشیه مشخص، و معمولاً با قطر 0.5 تا 1 میلیمتر هستند.
- نایسریا مننژیتیدیس (Neisseria meningitidis): متوسط تا بزرگ، خاکستری آبی و موکوئیدی.
موارد استفاده از تایر مارتین آگار اصلاح شده
- تایر مارتین آگار برای جداسازی باکتریهای نایسریای بیماریزا از نمونههای حاوی فلور که مخلوطی از باکتری و قارچ هستند، استفاده میشود.
- برای جداسازی و کشت گونههای نایسریا استفاده میشود.
محدودیتهای تایر مارتین آگار اصلاح شده
- برای تایید نهایی، آزمایشات بیوشیمیایی و سرولوژیکی اضافی توصیه میشود.
- جهت کشت نایسریاهای بیماریزا، محیط باید در حضور 3 تا 7 درصد CO2 انکوبه شود. غلظتهای بالاتر CO2 ممکن است برای برخی از سویهها عامل مهار کننده باشد.
- محیطهای انتخابی برای نایسریاهای بیماریزا ممکن است سایر باکتریهای بیماریزا مانند هموفیلوس (Haemophilus) را مهار کند.
- مهار سویههای نایسریا گونورهآ توسط مولفههای مهار کننده V-C-N و تریمتوپریم لاکتات گزارش شده است.
- در حالی که “ساپروفیت” نایسریا به طور کلی توسط محیطهای انتخابی سرکوب میشود، گاهاً بازیابی نایسریا لاکتامیکا ( lactamica) در محیط کشت تایر مارتین آگار اصلاح شده، گزارش شده است.
- برخی از سویههای گونه کاپنوسیتوفاگا (Capnocytophaga) ممکن است در این محیطهای انتخابی در صورت تلقیح با نمونههای اروفارینژیال (Oropharyngeal)، رشد کنند.
جهت خرید و یا استعلام قیمت با ما تماس بگیرید یا در واتسپ پیام بزارید
همچنین بخوانید:
- محیط کشت BSA: ترکیب، اصول، آمادهسازی، نتایج و کاربرد
- زاپکس آگار (محیط کشت CZA): ترکیب، اصول، آمادهسازی، نتایج و کاربرد
- محیط کشت CVA (کمپیلوباکتر بلاد آگار): ترکیب، اصول، آمادهسازی، نتایج و کاربرد
- هکتون انتریک آگار (محیط کشت HE): ترکیب، اصول، آمادهسازی و نتایج
مترجم: صادق حسینیکیا




